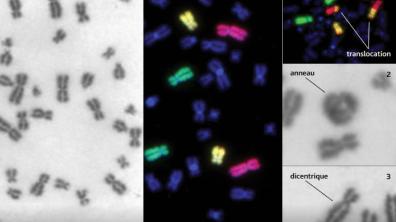

20 mSv
C’est la dose de rayonnement maximale à laquelle doivent être exposés les intervenants (Smur, pompiers…) lors d’une urgence radiologique. Seuls des personnels volontaires peuvent être exposés à un risque supérieur.
L’exposition directe à une source radioactive est un accident rare. Comment y répondre ? L’Institut et ses partenaires hospitaliers civils et militaires ont dans ce domaine une compétence reconnue. L’enjeu est désormais de se préparer à un accident impliquant un grand nombre de victimes.
Moins de victimes, mais des lésions plus sévères. L’accident radiologique, au cours duquel une personne est en contact avec une source radioactive de forte activité, se distingue de l’accident de réacteur, lors duquel des éléments radioactifs peuvent se disperser dans l’environnement. Le risque n’est plus d’inhaler ou d’ingérer des « poussières radioactives », mais d’être irradié sur de grands volumes corporels ou plus localement à de très fortes doses. Les rayons sont invisibles, ne dégagent ni odeur ni chaleur apparente, mais peuvent être très dangereux.
Ces vingt dernières années, la France a été engagée dans la gestion médicale d’une vingtaine de victimes irradiées. Elle est reconnue pour son expérience dans ce domaine et intervient sur différents accidents survenus à l’étranger. « L'OMS¹ et l’AIEA² reconnaissent l’expertise de la France dans ce domaine, et l’IRSN, en collaboration avec les hôpitaux civils ou militaires, a contribué aux missions d’assistance médicale déployées dans ces pays », rappelle le radiobiologiste Marc Benderitter. Pérou, Brésil, Équateur, Chili, Sénégal… la liste des pays qui font appel à l’assistance internationale et à l’expertise française s’allonge au fil des ans. « Souvent dans le secteur industriel, notamment dans l’industrie pétrolière et gazière, des appareils de radiographie sont utilisés pour vérifier l’étanchéité ou la qualité des soudures. La source éjectée de l’appareil peut être ramassée de façon fortuite et manipulée. Les conséquences sont alors dramatiques », raconte-t-il.
Si une source était détectée en France dans un lieu fréquenté, comment la réponse s’organiserait-elle ? « Les premiers acteurs projetés sur site seront les forces de police, les pompiers, la sécurité civile, éventuellement le Samu », enchaîne Marc Benderitter. Première mission : confirmer et caractériser la source radiologique. Les pompiers trient les victimes. Les éloigner de la source irradiante suffit pour les mettre hors de danger. Le périmètre est sécurisé. Si des particules radioactives ont été dispersées, les victimes doivent être décontaminées et recevoir des antidotes pour éliminer rapidement les éléments radioactifs incorporés et réduire le risque à long terme de développer des cancers. La prise en charge des personnes ayant pu être au contact de cette source s’organise, sur place et par des appels des autorités à se signaler.
Reste à soigner les personnes irradiées. Certaines peuvent être évacuées vers des hôpitaux civils ou militaires (HIA Percy) pour une prise en charge spécialisée. Un paramètre est alors crucial : la dose de radiations reçue et sa distribution. Car ce sont elles qui guideront le traitement. Une première méthode consiste à faire une analyse de sang pour compter les anomalies observées sur les chromosomes des lymphocytes T. « Les rayonnements ionisants cassent les deux brins d'ADN, explique en effet Gaëtan Gruel, chercheur en radiobiologie à l’IRSN. Les cellules ont des mécanismes de réparation, mais des erreurs peuvent survenir et conduire à la formation de structures chromosomiques anormales, issues de fusions de chromosomes. » Plus la dose reçue est forte, plus ces aberrations chromosomiques sont nombreuses.
Le Laboratoire de radiobiologie des expositions accidentelles (LRAcc), à Fontenay-aux-Roses, est le seul en France à pratiquer ces examens sur les populations civiles. Aurait-il des moyens suffisants pour répondre à un accident de grande ampleur ? « Nous pourrions prendre en charge jusqu’à 160 prélèvements simultanément », estime le biologiste. Avec l’appui du Laboratoire de biologie médicale et d’anthroporadiométrie (LBMA), au Vésinet, le seuil de 200 prélèvements analysés simultanément sera bientôt atteint. Chaque année, l’Institut consolide ses méthodes avec des exercices durant lesquels des quantités massives d’échantillons sont soumises. L’intelligence artificielle3 est à l’étude pour accélérer encore le processus.
La méthode a malgré tout des limites. « Il s’écoule au minimum quarante-huit heures entre le prélèvement et l’arrivée des résultats. Et c’est une dose moyenne qui est mesurée », relève Christelle Huet, physicienne experte en dosimétrie externe. Impossible de connaître les organes les plus touchés. Une autre technique consiste à reconstituer la dose reçue en chaque partie du corps par des simulations numériques. « Mais il faut connaître le scénario d'exposition », prévient la physicienne.
Le premier travail consiste donc à identifier les caractéristiques de la source, son niveau de radioactivité, à reconstituer la disposition des victimes, etc. (voir l’infographie – Irradiation : reconstituer les doses reçues avec le logiciel Seed). En complément, des techniques comme la spectroscopie à résonance paramagnétique électronique permettent d’estimer la dose reçue par des échantillons biologiques (émail dentaire, ongles et os), ou sur des objets portés (écrans tactiles de téléphone portable, sucres, polymères, etc.). La comparaison de toutes ces données (mesurées et simulées) permet de valider ou d’affiner le scénario de l’irradiation et de déterminer de manière précise les doses aux organes.
Les médecins peuvent alors mettre en place les soins les mieux adaptés. Comme dans le cas d’une contamination nucléaire (voir l’article « Intervenir auprès des populations exposées »), cette prise en charge médicale fait intervenir, à travers le dispositif Orsan, un établissement de santé de référence : La Pitié-Salpêtrière, au niveau national, ou un centre hospitalo-universitaire (CHU), à l’échelon régional. Ce dispositif prévoit également la possibilité de mobiliser les hôpitaux du service de santé des armées. Chargés de centraliser la réponse, ces établissements référents assurent la prise en charge des patients et doivent être préparés en conséquence. À ce titre, ils sont garants de la formation au risque radiologique des professionnels de santé et de la disponibilité des traitements. Ils développent aussi le réseau régional de santé pour le risque radiologique et nucléaire. Pour que personne ne soit pris au dépourvu quand l’accident survient.
1. Organisation mondiale de la santé
2. Agence internationale de l’énergie atomique
3. Voir l’article « Radiobiologie : l’intelligence artificielle en cas d’urgence » https://reperes.irsn.fr/temps-forts/radiobiologie-lintelligence-artific…
Comment gérer un accident radiologique de grande ampleur et déterminer au plus vite quelles victimes requièrent des soins ? Pour modéliser l’irradiation produite par une source radioactive, l’IRSN développe depuis 2016 le système autonome Seed (Simulation des expositions externes et dosimétrie), en partenariat avec le service de protection radiologique des armées (Spra).
C’est la dose de rayonnement maximale à laquelle doivent être exposés les intervenants (Smur, pompiers…) lors d’une urgence radiologique. Seuls des personnels volontaires peuvent être exposés à un risque supérieur.
Guide national d’intervention médicale en situation d’urgence nucléaire ou radiologique : https://www.asn.fr/l-asn-reglemente/guides-de-l-asn/guide-national-d-in…
Repères n° 56, pp. 22-23 (Reportage) « Accident radiologique, trier des victimes grâce aux analyses ».
Article publié en octobre 2024